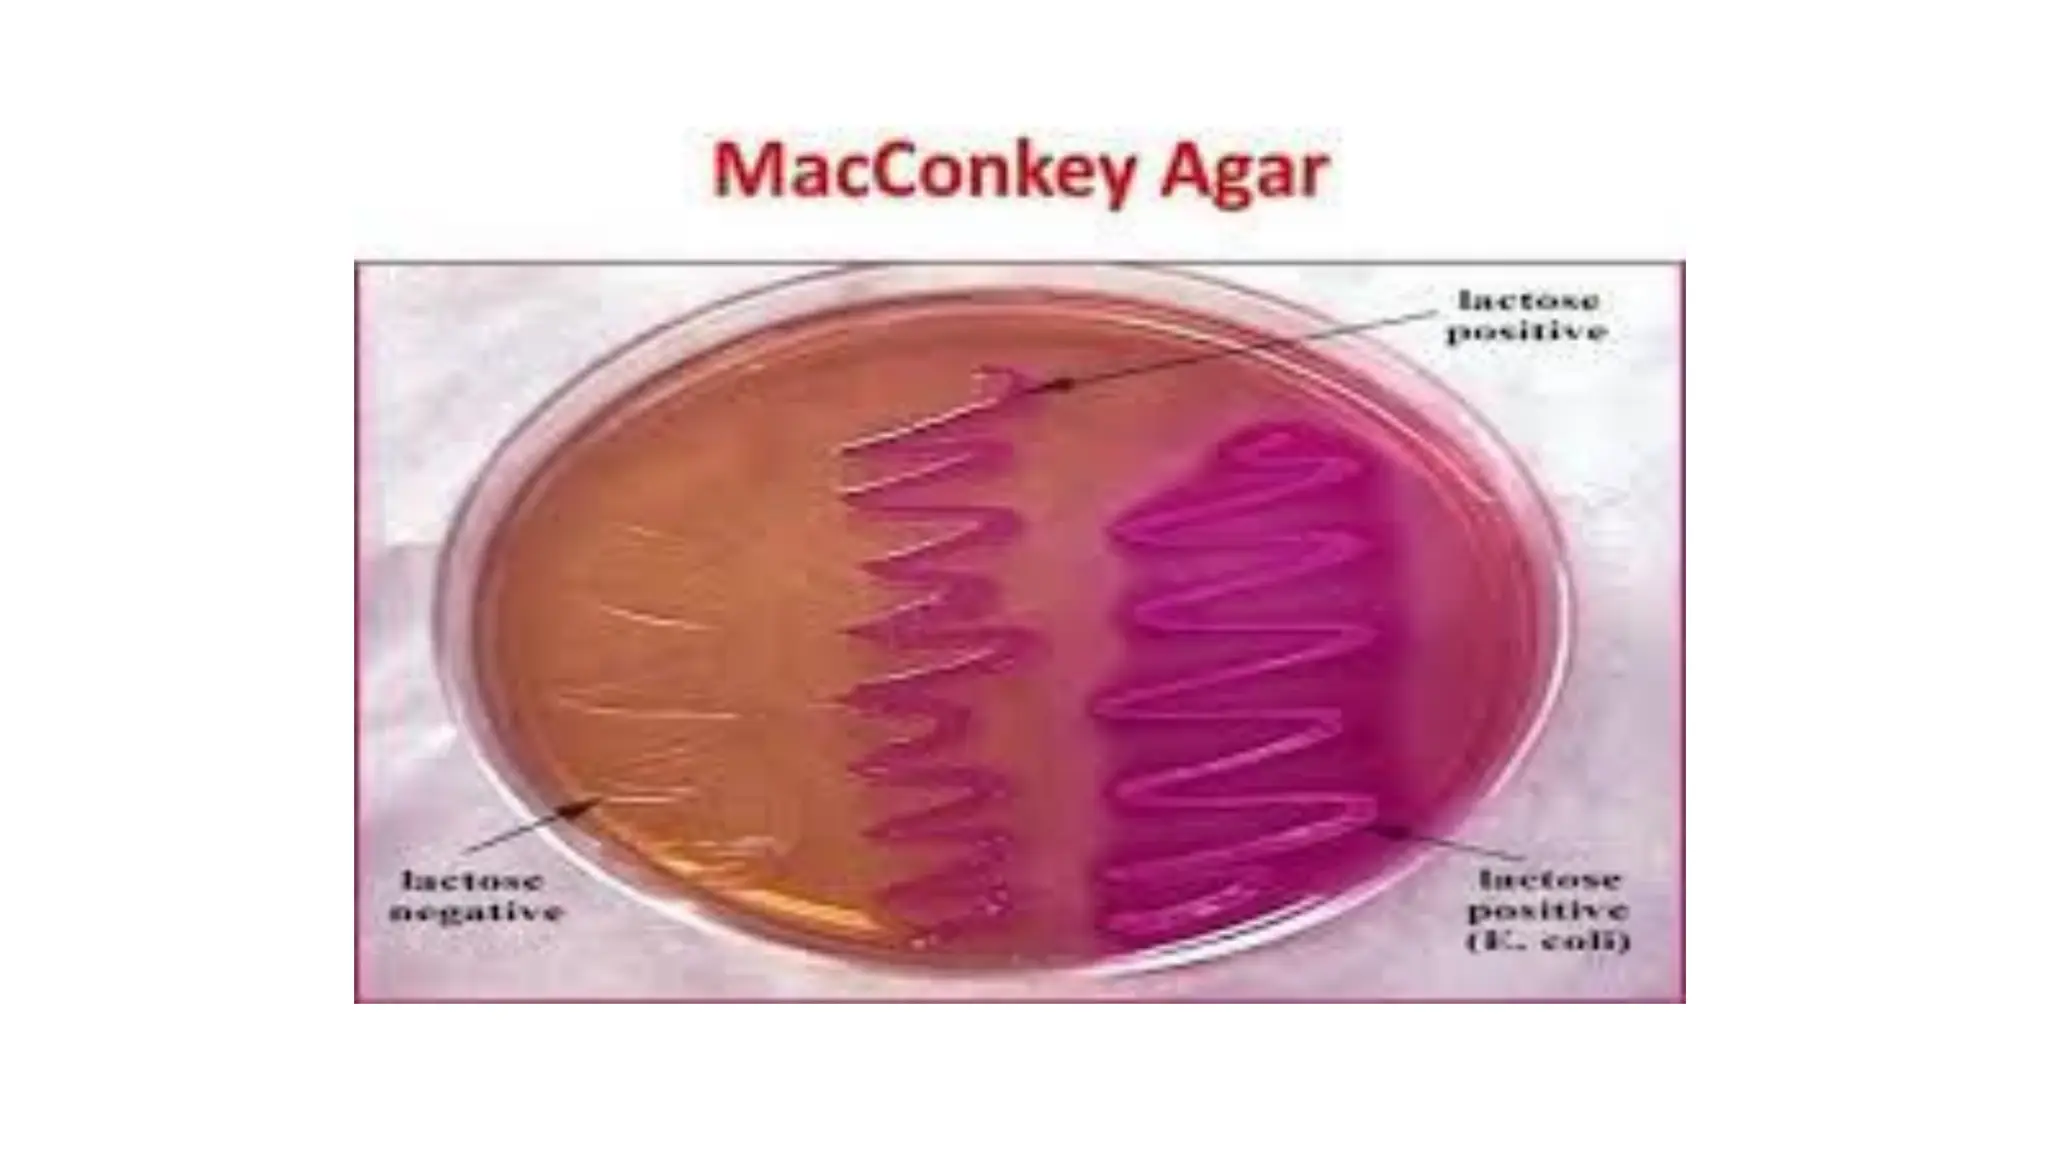

Embed presentation
Download to read offline





















This document discusses tests used to analyze stool samples, including transporting stool in a buffered salt solution and culturing it in various media like SIM, TSI agar, and sugars to identify bacteria through processes like sulphur production, indole formation, motility, citrate use, and fermentation. These tests help identify bacteria in the GI system and determine pathological states.